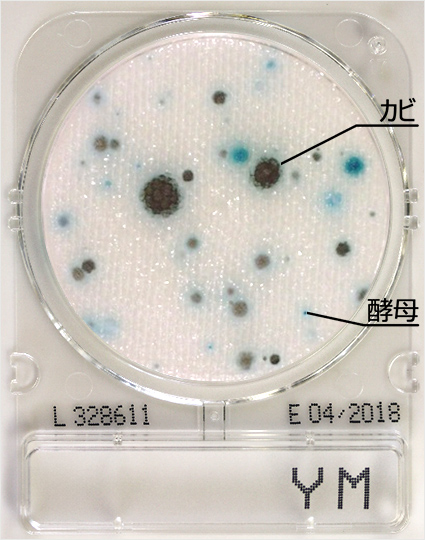
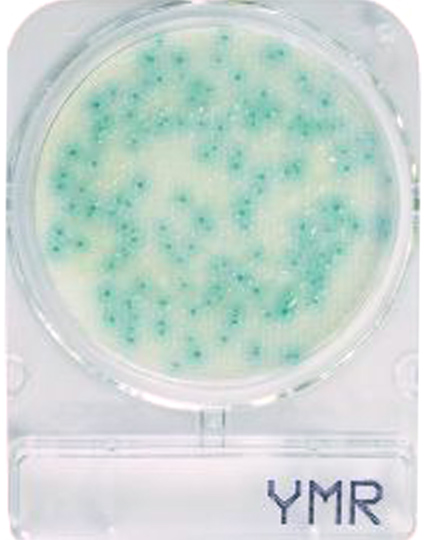
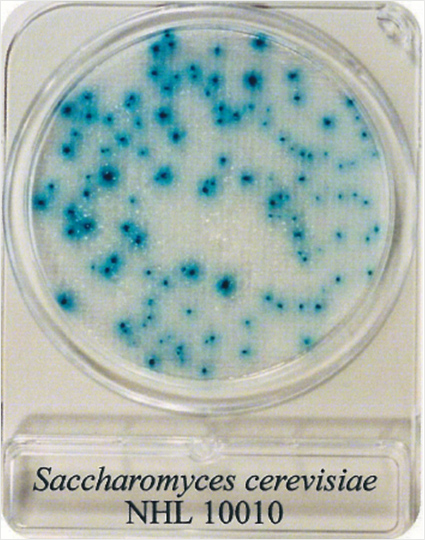
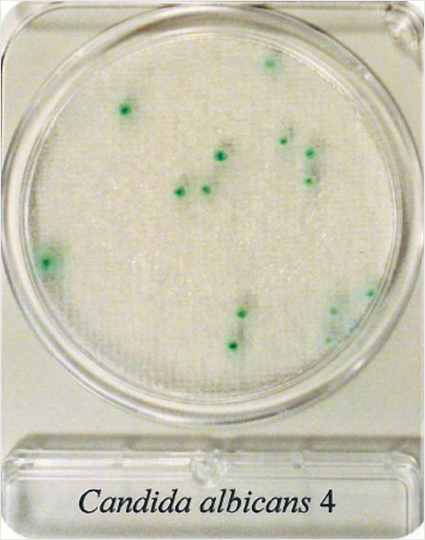
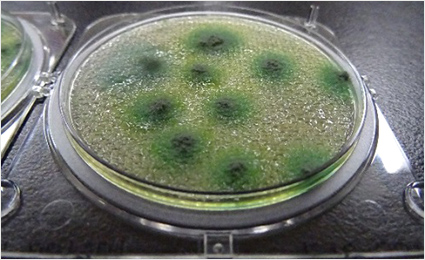
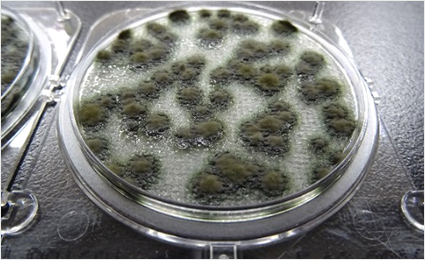
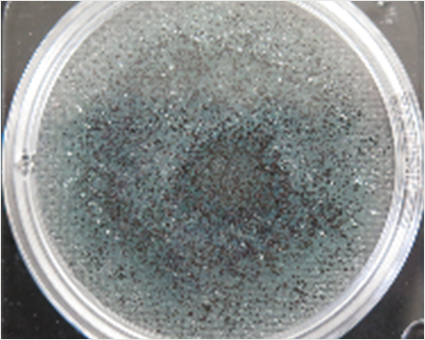
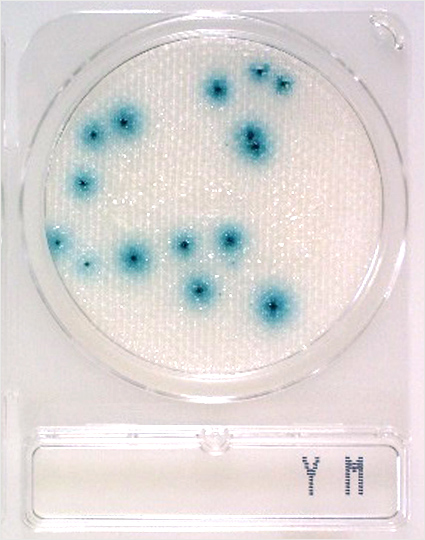
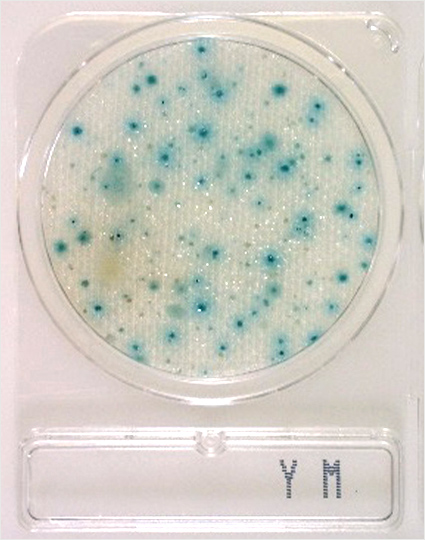
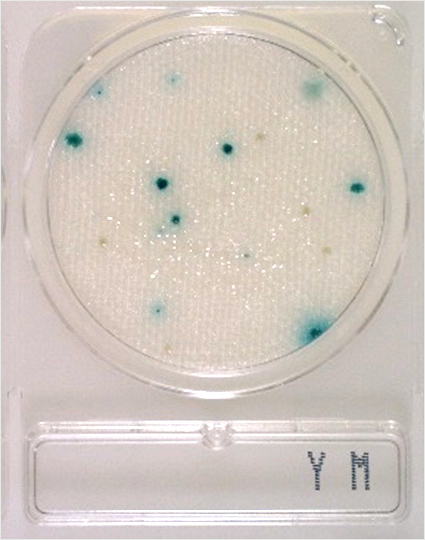
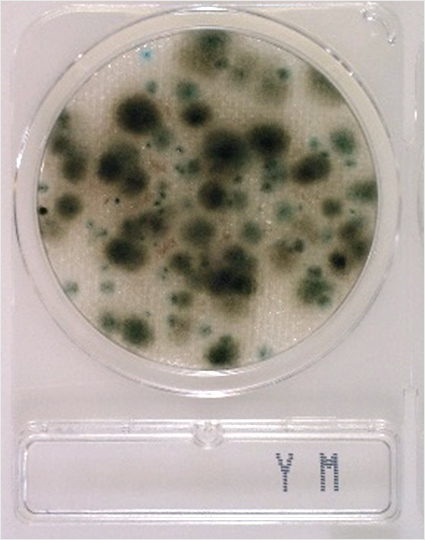
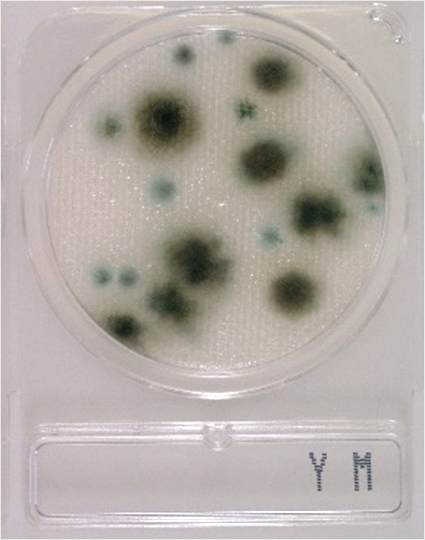
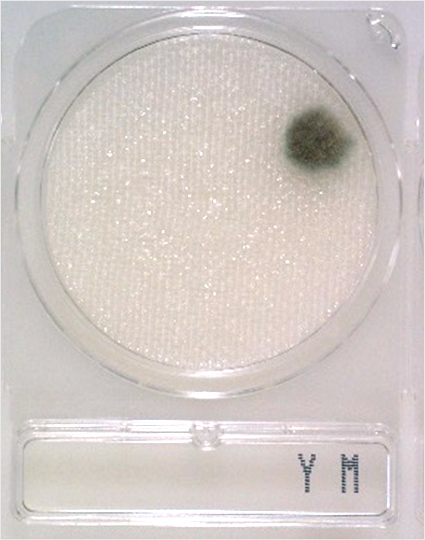
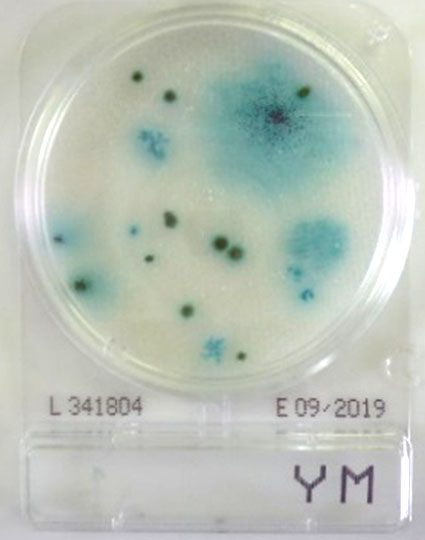
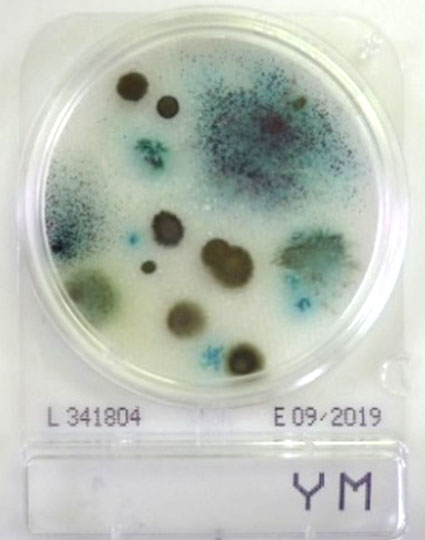
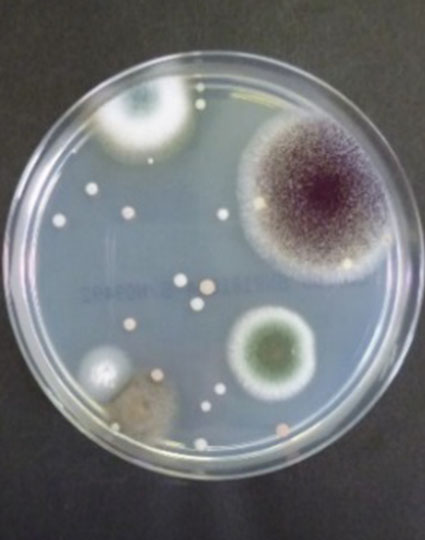
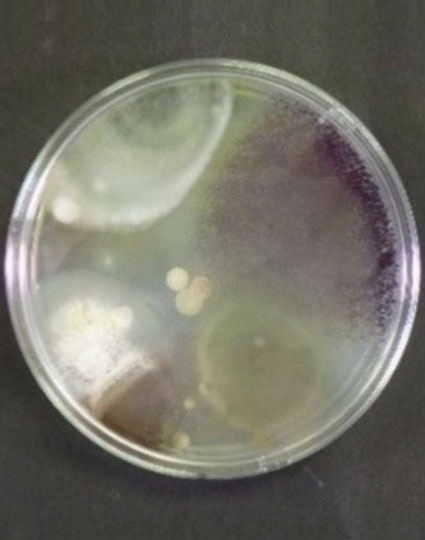

コンパクトドライ™ 判定ガイドコンパクトドライ™ YM・YMR
本ガイドは、コンパクトドライ™ YM・YMRの培養結果について適切に理解していただくためのものです。その他の製品については以下をご参照ください。
コンパクトドライ™ YM・YMR
| 用途 | 酵母・カビ測定用 |
|---|---|
| YM | Yeast & Mold |
| 認証 | AOAC-PTM認証/MicroVal認証/NordVal認証 |
| 特長 | ・カビの菌種特有の胞子の形状や色の観察が可能 |
| 判定方法 | 25±1℃ 3~7日 酵母:緑~青色または白色~クリーム色のコロニー カビ:カビ自体の着色した綿状のコロニー |
| 用途 | 酵母・カビ測定用(迅速タイプ) |
|---|---|
| YMR | Yeast & Mold, Rapid |
| 認証 | AOAC-PTM認証/MicroVal認証/NordVal認証 |
| 特長 | ・カビの菌種特有の胞子の形状や色の観察が可能 ・コンパクトドライ YMの迅速タイプ |
| 判定方法 | 25±1℃ 2~3日 酵母:緑~青色または白色~クリーム色のコロニー カビ:カビ自体の着色した綿状のコロニー |
※YMとYMRは、培養時間が異なりますが、判定方法は同一ですので、両製品ともにこの判定ガイドを参照してください。
カビと酵母のコロニー(純培養菌接種例)
酵母は比較的輪郭のはっきりした丸いコロニーを形成し、発色酵素基質X-Phosによりコロニー自体や周辺培地を青~緑色に発色させます。
発色しない酵母もありますので注意が必要です。シャーレの背景を黒色バックで観察すると、白いコロニーが見やすくなります。

ページ上部のジャガイモ 102倍希釈の写真のように、カビは、大きく広がったカビ自体の色(酵素基質により青く染まることもあります)のコロニーを形成します。
3日培養ほどから、カビの胞子が肉眼で立体的に観察できます。5~7日培養でカビは特徴的コロニーへ成長します。

コンパクトドライにカビのジャイアントコロニーを形成させると、カビの菌種特有の胞子の形状や色を観察できます。
※コンパクトドライのフタを開けるとカビの胞子が飛散しますので、フタを開けずに観察してください。フタを開けるときは、安全キャビネット内で行うなど、バイオハザード対策をとったうえで観察してください。
ジャイアントコロニーの形成

いろいろな食材の培養例
カット野菜、浅漬けキャベツでは、酵母が優位に検出され、浅漬けキャベツには発色しない酵母が認められます。
カット野菜

浅漬けキャベツ

ミニトマトでは黒色のカビ、発色酵素基質により青く発色したカビ、2種類のカビが認められます。
ミニトマト

牛レバー、しいたけでは、培地シート全体にうっすらとした発色が見られました。シート全体が発色する原因には、接種された菌数が多い、食品自体が酵素基質と反応しているなどがあります。この場合、前後の希釈段階のコロニー数を観察することで原因の特定が可能となります。
動物の臓器、野菜原料の一部では発色酵素基質と反応するものがありますので注意してください。牛レバー、しいたけ、いずれの例でも、うっすらとした発色の中に比較的濃い発色のコロニーが観察できます。
牛レバー



しいたけ



コンパクトドライ YMを使った落下菌検査 培養時間とコロニー数
コンパクトドライ YMとCP加ポテトデキストロース寒天培地(9 cmシャーレ分注)を同じ箇所に一定時間開放した後培養し、時間を追ってコロニーの状態を観察したところ、両法のコロニー数には高い相関が得られました。なお、コンパクトドライと9 cmシャーレの面積比(19.6/63.6=1/3.24)から、両結果を比較する場合はコンパクトドライで得られたコロニー数に3.24を掛け換算してください。
7日目まで培養するとカビのコロニーが広がりカウントしにくくなることがありますので、3日目時点で油性ペン等で培地裏面にコロニーカウント結果を残し、7日で最終判定することをお勧めします。
コンパクトドライ YM

CP加ポテトデキストロース寒天培地